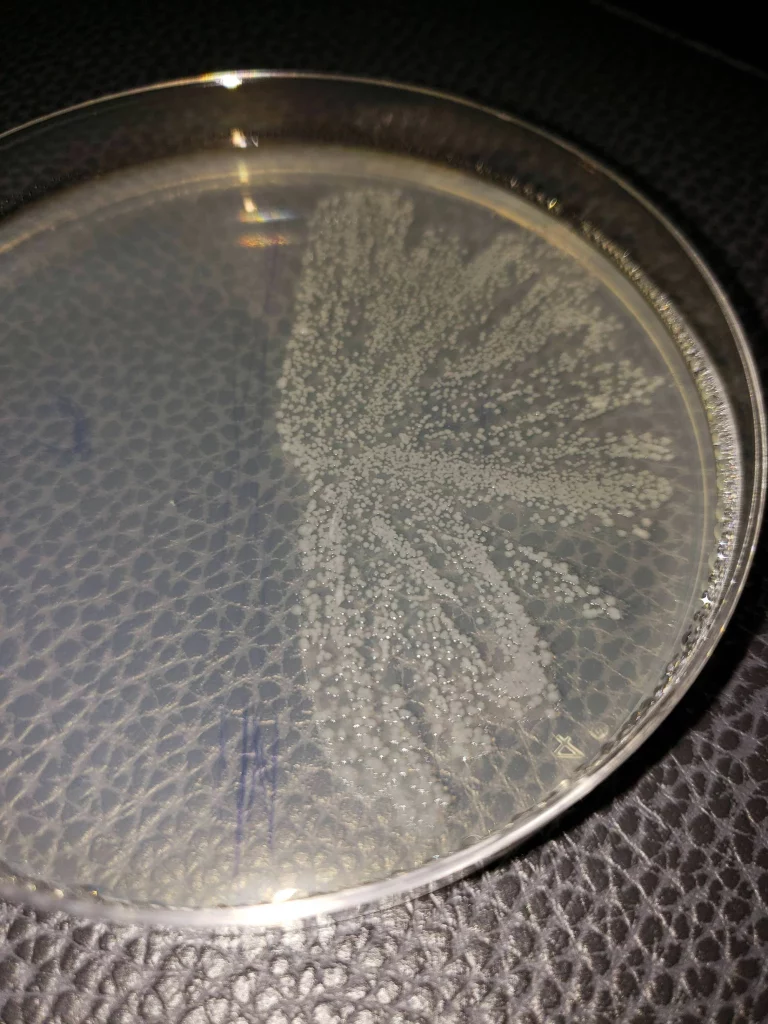

What Is Sea Moss And Why Is It Good For You
1. Sea moss is a type of seaweed

Image Source: Salon.com
Ever heard of sea moss? It's definitely not something you would come across in your everyday life! But it's exactly what it sounds like: a type of sea vegetable that grows at the bottom of the ocean. It's very similar to algae or seaweed and can be yellow, gold, red, blue or green.Advertisement
2. It's used to make carrageenan

Image Source: Pinterest
Sea moss is most commonly harvested for a really important ingredient: carrageenan. This is a naturally occurring gelatinous substance in sea moss that is used to thicken foods. You might see carrageenan on the list of ingredients in your makeup or in dairy products or meat.Advertisement
3. Which has been used in Chinese medicine for years

Image Source: Reddit
But in fact, though it's most commonly harvested for carrageenan today, sea moss has been a staple of Chinese medicine for thousands of years. In Traditional Chinese Medicine (TCM), sea moss is said to resolve water accumulations in the body and eliminate toxins from cells. But the West is only now getting acquainted with sea moss' many, many health benefits.Advertisement
4. There are tonnes of health benefits

Image Source: Reddit
In fact, today, sea moss is seemingly advertised everywhere. One of the biggest celebrities to advertise sea moss is Kim Kardashian, who says that she adds it to her daily smoothies and called it a superfood. Kourtney Kardashian also loves sea moss - she said that the sea vegetable is great for "mind, body and beauty". Pretty high praise, coming from the biggest health and beauty influencers in the world!Advertisement
5. Some you might not expect

Image Source: tumblr.com
Considering it's a staple of Chinese medicine, you're probably already realising that sea moss is good for you. But actually, this weird algae-like veg can benefit your entire body, preventing horrific diseases, improving your skin, and helping you stay healthy like no other superfood can.Advertisement
6. It's great for your thyroid

Image Source: mossupyourlife.com
For starters, sea moss is really good for your thyroid. As with most seafood, sea moss contains iodine, which is super important for your thyroid. The thyroid produces hormones that can affect a whole host of things in the body, particularly in women - so getting enough iodine is really important.Advertisement
7. Which could help you avoid weight gain

Image Source: archziner.com
Eating sea moss, which contains heaps of iodine, can improve the function of your thyroid. One of the things your thyroid does is produce hormones for your metabolism. Thus, eating sea moss can help your metabolism function correctly and help prevent you from gaining weight.Advertisement
8. It could improve heart function

Image Source: tumblr.com
Iodine isn't just good for your thyroid, though. This vital nutrient can also support the health of your heart. Sea moss also contains antioxidants which can help your blood system thrive and lower the risk of you developing heart disease. Considering the heart is one of the most important organs in the body, it probably pays to try sea moss.Advertisement
9. And might lower your blood pressure

Image Source: wikimedia.org
There are some reports can sea moss can actually help thin blood. This benefit, along with improving overall heart and blood health, may help you to lower your blood pressure. Keeping your blood pressure at a healthy level has benefits for the entire body, including your immune system and heart health.Advertisement
10. Carrageenan lowers blood sugar levels

Image Source: Reddit
Evidence suggests that increasing your intake of carrageenan can actually help lower your blood sugar levels, too. Everyone can experience the benefits of low blood sugar, even if you don't know what that means. Being able to maintain a steady blood sugar level will help you lose weight and can improve overall cardiovascular health.Advertisement
11. Meaning it's great if you've got diabetes

Image Source: Reddit
However, being able to maintain low blood sugar levels is particularly important for people with diabetes. If you have diabetes, it means your blood sugar levels are consistently higher than normal. Being able to reduce these can help your overall health, and if you have type 2 diabetes, it could even increase your chance of putting your diabetes into remission.Advertisement
12. Sea moss can fight free radicals

Image Source: Insider.com
We've already mentioned that sea moss contains tonnes of antioxidants, and these are especially important for fighting free radicals in the body. If they sound bad, it's because they are. Free radicals are unstable atoms that can cause damage to the body - in some cases, even causing cancer.Advertisement
13. And could slow cancer tumour growth

Image Source: rarevibezhh.com
So, sea moss can fight the atoms that can cause cancer. But did you know that sea moss may also slow down the growth of cancerous tumours in the body? Some studies suggest that because of its strong antioxidant properties, it can help fight particular cancers, including skin cancer.Advertisement
14. It contains healthy skin vitamins

Image Source: tumblr.com
But sea moss is good for the skin in many other ways. As well as iodine, sea moss contains vitamins, including magnesium, vitamin A, vitamin K, and omega. What do all of these nutrients have in common? They're great for the skin! So, eating sea moss can keep your skin looking and feeling healthy.Advertisement
15. And can give you a boost of hydration

Image Source: pinterest.com
Sea moss doesn't have to be eaten to help your skin, though. Many skincare products include sea moss in the ingredients list because it can have an instant effect on boosting your skin cells and improving hydration. Keeping your skin hydrated is a vital skin care tip - nobody wants dry, dead skin.Advertisement
16. It might prevent Parkinson's

Image Source: pinterest.com
Parkinson's Disease is the second-most common degenerative disease in older adults. It can be devastating for families, especially as it only gets worse with time. However, if you want to prevent your risk of developing Parkinson's in the first place, you could do worse than introduce sea moss into your diet. Some studies have shown that it may be able to slow the progression of the disease.Advertisement
17. And improve your immune system

Image Source: tumblr.com
The immune system is so important. In the winter, your immune system will help you fight off colds and other illnesses, while at other times of the year, it's also important to fight toxins in the body. Sea moss can help your immune system thanks to its antioxidant and anti-inflammatory properties, while it may also help your kidneys remove excess sodium from the body.Advertisement
18. Pregnant? You should consider using sea moss

Image Source: tumblr.com
Sea moss is totally safe to eat while pregnant - which is a great thing. If you're pregnant, you should really be taking advantage of all the health benefits of sea moss, which include supporting your hormones, boosting your iron intake, and supporting the neurological development of your baby.Advertisement
19. It'll also improve your hair growth

Image Source: pinterest.com
Back to cosmetic benefits now (which, for some readers, might be more important than its other health benefits!) Sea moss is packed full of so many nutrients, all of which can help support the growth of healthy, glossy, strong hair follicles. It may also provide some relief from irritated scalps and thin, breakable hair.Advertisement
20. And prevent hair loss

Image Source: weloveit.com
Primarily, though, sea moss can help boost natural hair growth. Sea moss contains lots of folic acids, one of the main nutrients responsible for creating new hairs. As a result, eating sea moss regularly can help speed up hair growth and prevent hair loss. So, if you want long, beautiful hair, get some sea moss.Advertisement
21. It can stop salmonella

Image Source: baucemag.com
We know that sea moss can help the body's immune system. However, it's also great at fighting off really particular illnesses - including salmonella. This is because sea moss contains substances that can fight off S. Enteritidis, the main bacteria that causes salmonella.Advertisement
22. It's got a tonne of fiber in it

Image Source: Reddit
Okay, okay - I know this list of nutrients is getting ridiculous. But yes, sea moss also contains lots of fiber, which is really important for your body's digestive system. Eating lots of fiber can also help keep your blood sugars at normal levels and keep you full for longer, reducing your chance of weight gain.Advertisement
23. And it's a great source of live bacteria
Image Source: Reddit
Live bacteria doesn't necessarily sound like something you want to willingly ingest. But trust us - this is really good bacteria. Your gut contains lots of important bacteria that support a healthy body, and eating sea moss can help replenish some of these good bacteria, keeping you feeling good.Advertisement
24. Sea moss can also help weightlifters

Image Source: Reddit
We know this one's pretty niche, but are you a weightlifter? If so, you should definitely try sea moss. It's actually the only sea vegetable that contains rich quantities of taurine, an amino acid that can support muscle recovery and growth. So, if you want to see results more quickly, consider adding sea moss to your regime.Advertisement
25. It'll give you more energy

Image Source: weheartit.com
Iron is really important if you're pregnant, but really everybody should be trying to get enough iron into their body. This is because it can help with your energy levels and reduce tiredness. Luckily, sea moss contains lots of iron, making it a great supplement to take, especially if you have periods.Advertisement
26. And help your brain

Image Source: Reddit
Brain health is so important. Keeping your brain active and healthy will prevent your risk of developing certain neurological disorders and keep you sharp into your old age. Sea moss contains lots of magnesium and potassium, both of which are really important for overall brain health, and may improve your mood, too.Advertisement
27. It'll also help in the bedroom

Image Source: tumblr.com
In the Caribbean, sea moss is a common sexual enhancement product - and it really can help. Sea moss can increase libido and reduce the chance of pain during intercourse, making for better times in the bedroom. It may also improve your sex drive overall - no bad thing.Advertisement
28. And boost your antibodies

Image Source: tumblr.com
One study found that rats who ate lots of sea moss actually produced more antibodies than those who didn't eat the sea moss. While reports are not as conclusive in humans, it's always worth increasing your antibodies as they help cleanse your body of toxins and fight illnesses.Advertisement
29. As well as reduce pain

Image Source: eBay
Sea moss contains lots of amino acids and proteins. While for weightlifters, this is really important, it can also help everyone to reduce their tiredness and fatigue. Sea moss can also help prevent inflammation, reducing overall pain levels in the body. So, if you have chronic pain, it might be worth a try.Advertisement
30. So, what are you waiting for?

Image Source: voirfashion.com
Did you expect sea moss to have so many health benefits? We certainly didn't. But this sea plant is really a miracle food, helping all parts of your body from your brain to your skin and heart. If you're interested in getting sea moss into your diet, you can buy it from many health food stores - but start with just one teaspoon a day.Advertisement
